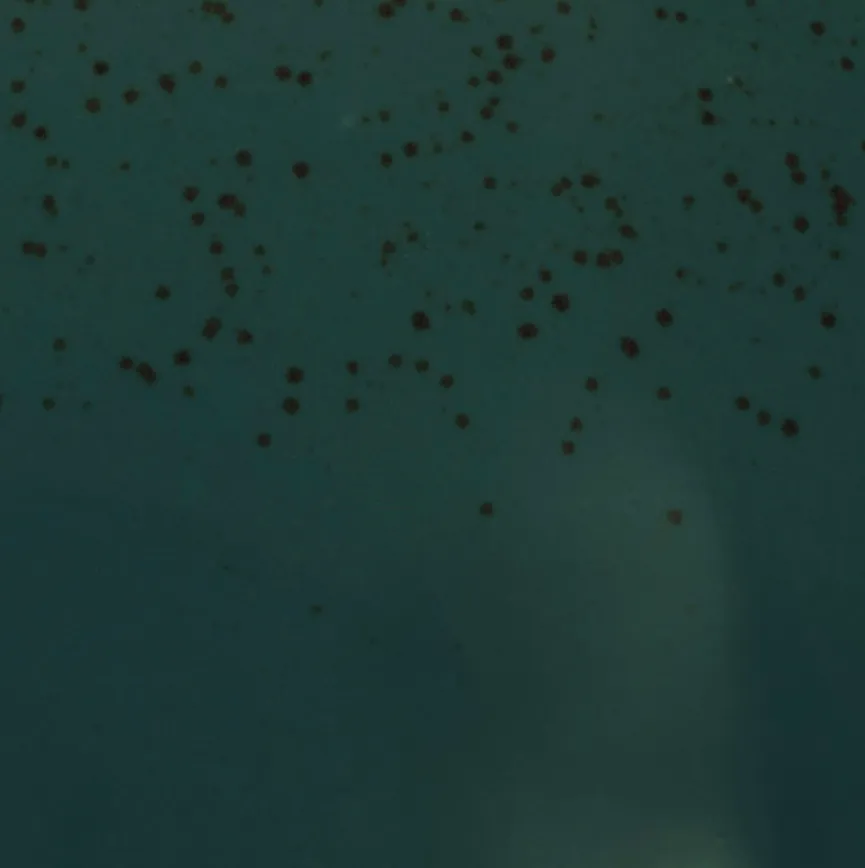
Speiseteller material_farbe
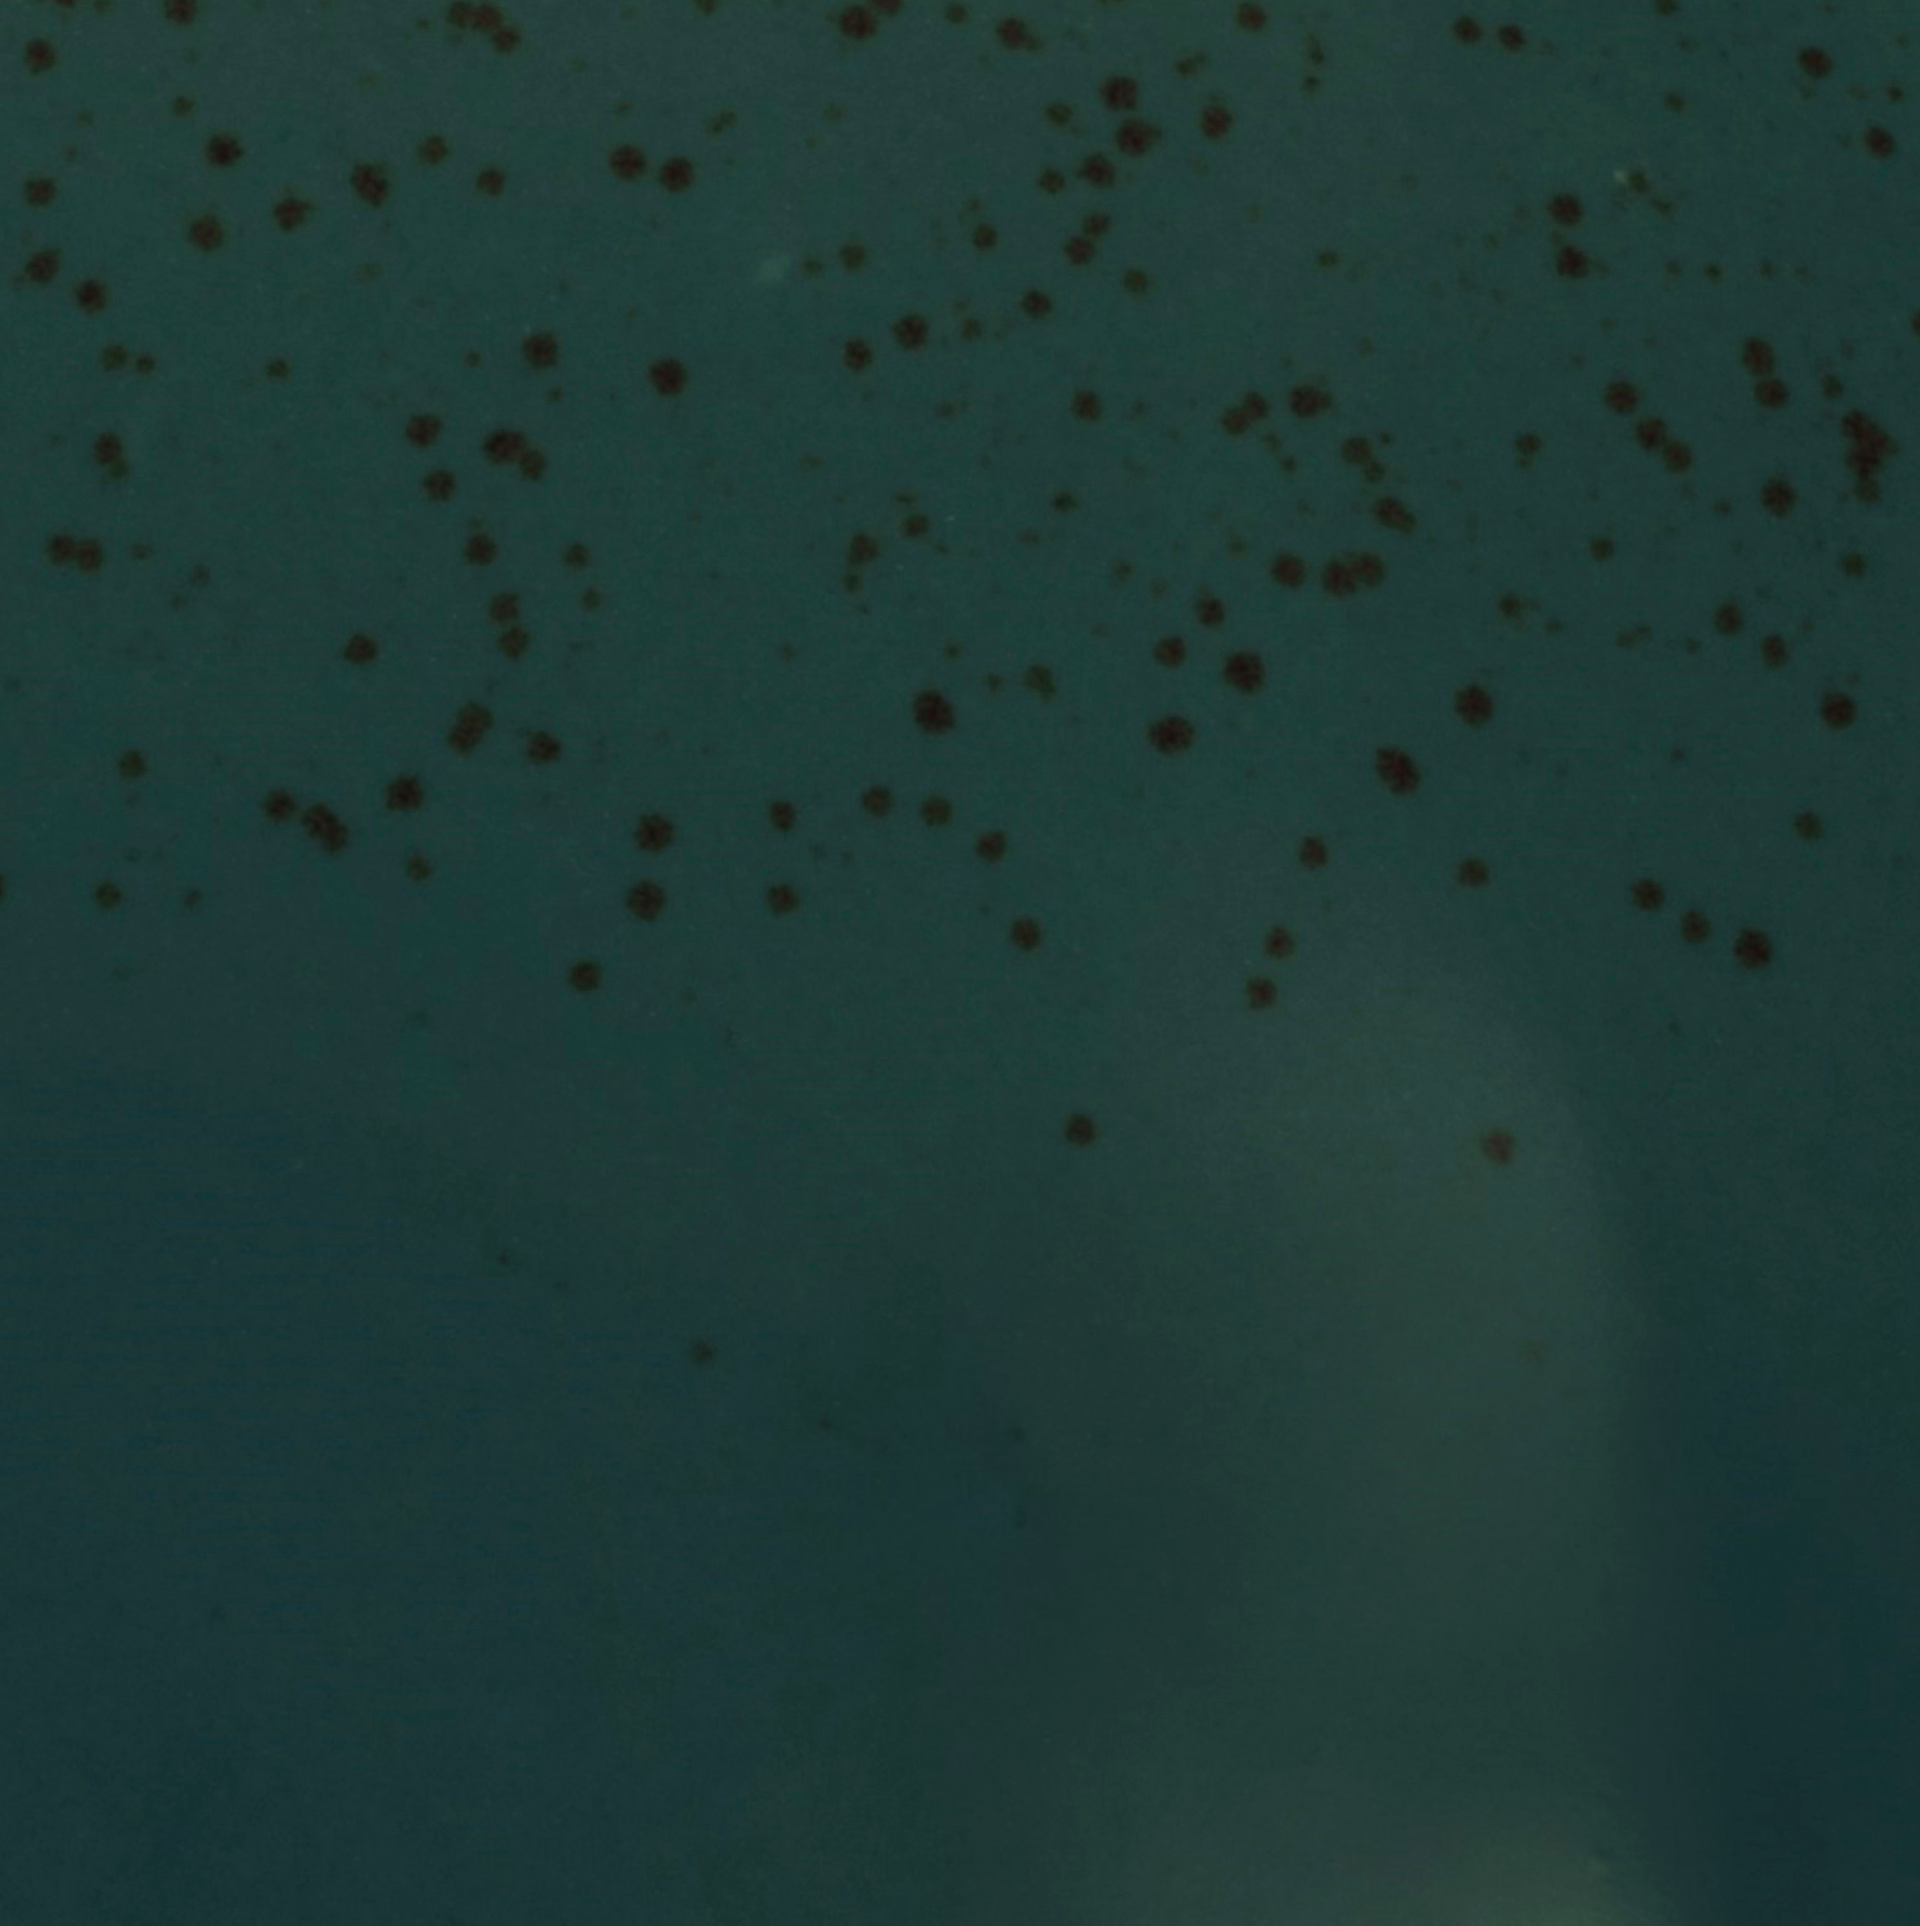
Speiseteller material_farbe

SpeisetellerNature Collection Ø 27 cm
CreaTable








Filialverfügbarkeit & Selbstabholung
Click & Collect prüfen oder vor Ort entdecken
Artikel Speiseteller Nature Collection Ø 27 cm Artikelnummer 3668555-00000Marke CreaTableMaterial Steinzeug
Highlights
- Aus Steinzeug
- Ø 27 cm, Höhe 3,5 cm
- Aus der Serie Nature Collection
Weitere Produktdetails
| Mikrowelle: | mikrowellengeeignet |
| Spülmaschine: | spülmaschinengeeignet |
ProduktabmessungenDurchmesser in cm27.00
Auf dem stilvollen Speiseteller Nature Collection Ø 27 cm von CreaTable kommen Ihre Mahlzeiten besonders gut zur Geltung. Eine spezielle Reaktivglasur sowie dekorative Sprenkel sorgen dafür, dass sich der ansprechende Essteller durch ein gewisses Etwas auszeichnet. Zelebrieren Sie mit dem geschmackvoll gestalteten Speiseteller Nature Collection Ø 27 cm die gehobene Tischkultur!
Paketanzahl:1
Lieferung per PaketKleinere Artikel versenden wir als Paket an Ihre Wunschadresse - zu Ihnen nach Hause, an Freunde oder ins Büro. In der Regel können Sie Ihre Bestellung schon innerhalb von wenigen Werktagen in Empfang nehmen.
Kostenlose Retoure per PaketIhr Wunschartikel gefällt Ihnen nicht oder weist Mängel auf? Kein Problem. Drucken Sie bitte den Ihrer Versandmitteilung angehängten Retourenschein aus und senden sie ihn bitte mit dem der Lieferung beigefügten Retourenaufkleber an uns zurück. Einzelheiten hierzu finden Sie direkt in unseren AGB.
| Allgemeiner Warn- und Sicherheitshinweis: Bitte halten Sie Verpackungsmaterial und mögliche Kleinteile aufgrund Erstickungsgefahr stets von Kindern und Babys fern. |
| Weitere eventuell vorhandene Warn- und Sicherheitshinweise entnehmen Sie bitte den hinterlegten Dokumenten unter „Montage und Dokumente“. |
CreaTable PorzellanHaus GmbH
Zur Fabrik 6
66271 Kleinblittersdorf
info@creatable.de